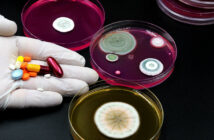

Szakirodalmi kutatások és sörfőzési kísérletezések indultak a középkori magyar sörfőzés hagyományának felélesztésére.
Pelles Márton sörfőző a Pro Scientia Aranyérmesek Társaságának (PSAT) Szegeden tartott konferenciáján elmondta, hogy a kísérletezés és a kutatás arra fókuszál, hogy „fel tudnak-e támasztani” olyan középkori magyar sörtípusokat, amelyek a mai fogyasztók számára is élvezetes sörökké tudnak válni. Kiemelte: vannak olyan kiadványok, amelyekben a középkori Magyarország sörtípusai és azoknak fűszerei szerepelnek. A kísérletekből pedig az derül ki, hogy melyik fűszerekkel működne ma is jól a sörfőzés, és melyekkel nem.
Bízom benne, hogy a jövőben lesz olyan főzde, amelynek üzemeltetői meglátják a lehetőséget a középkori magyar sörökben”
– hangsúlyozta Pelles Márton. Az 1500-as évek elejétől korlátozták a sörök fűszerezését a komlóra, de korábban, a középkori Magyar Királyságban különböző fűszereket is használtak, például köménymagot, gyömbért és borsikafüvet is – ismertette Pelles Márton.
A magyar sörfőzés hagyományáról elmondta, hogy már az Árpád-korban több liter sörrel adóztak évente házanként a magyar jobbágyok, a dömösi prépostság pedig évi csaknem 16 ezer liter sört adózott. A 14. században kialakultak az első sörfőzdék, de később, a török idők után a német sörhagyományok vették át az uralmat, és a magyar történelmi sörfőzés egy kissé feledésbe merült. Éppen ezért tesznek kísérletet arra, hogy hagyományos sörfajtákkal élesztenék újra a történelmi magyar sörfőzést – húzta alá.
Forrás: MTI